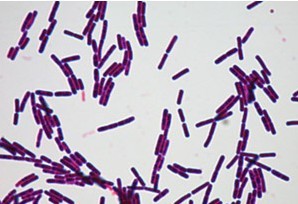
怀疑肺结核一定要查三次痰吗,医生怀疑是肺结核的几率有多大

一位28岁的女性,单位体检,做了个胸片,提示左上肺有个阴影,建议进一步检查。
后来又做了个CT,提示炎性病灶,不排除肺结核。
医生建议住院检查、治疗。
她没有什么症状,要说咳嗽,平时也是偶尔咳一两句。没有发热,食欲也好,也没有觉得很累,体重一直保持一定的水平。没有明确的接触过肺结核患者。
只是,最近好像有些烦,晚上感觉尤其明显,夜间似乎有些出汗,但她认为是太热的缘故。
住院期间,做过痰检、结核抗体IgG、血常规、C反应蛋白,都没有什么。
有问题的是PPD试验起水泡,结核感染T细胞试验(T-SPOT)阳性,血沉快。
这是很多疑似肺结核患者,通常所能够提取到的有用的资料。
经过抗感染治疗两周,患者复查了一次CT,病灶并没有明显吸收。
医生最终还是考虑肺结核,但也仅仅是“可能性的诊断”,建议患者尝试性的抗结核治疗。
抗结核治疗两个月后,患者自觉好些了,复查肺部CT发现病灶明显吸收。

另外一个病例,男性,46岁,爱游泳,平时身体很棒,因发热、咳嗽就诊,肺部CT提示右上肺结核灶。
入院后,检查发现白细胞高,C反应蛋白高,痰多,呈黄色或灰色。
痰检阴性、T-SPOT阳性、PPD阴性。
医生的诊断是打了问号的肺结核和肺炎,正要抗结核治疗,患者也准备吃药。
不料,用抗菌药2~3天后,患者症状明显好转,正好是周末,就没有给开抗结核药。
一周后,为了稳妥起见,复查了一下肺部CT,发现所谓的“结核病灶”竟然明显吸收。
患者所用药是“头孢”,对结核分枝杆菌是没有效果的。
这位患者后来继续原方案治疗,病灶完全吸收了。

两个有些相似的病例,起初都怀疑肺结核,最后的诊断不一样,治疗也不一样,都取得了好的效果。
这是目前肺结核的诊断过程中,经常碰到的事情。

很多怀疑肺结核的患者,都未能在痰中找到结核分枝杆菌,导致诊断和排除结核困难。
今天,龙大夫就带大家了解一下,结核是怎么诊断的。
肺结核最好的确诊方式,是病原学诊断。
病原学诊断,就是在病人的痰液、分泌物或者病理组织里面,直接涂片找到结核杆菌,或者培养出结核杆菌,或检测出结核杆菌的核酸(DNA)。

其次,是病理诊断。
病理诊断,是通过病理组织切片,虽然可能找不到结核杆菌(细菌可能死亡了),但是可以发现结核病灶,一般表现为典型的干酪样坏死病灶(外观就像干的奶酪一样),结核的可能性是非常大的。
- 细菌学检查,是用来确诊的。
细菌学检查,包括痰液结核杆菌涂片,也叫抗酸染色。如果在痰液中找到了抗酸杆菌,是可以确诊的。
其次,是结核杆菌的培养,由于结核杆菌生长缓慢,培养需要很长一段时间,通常需要2~4周左右的时间,结核杆菌菌落才能够长出来。
除了使用痰液,也可以使用一些分泌物和支气管灌洗液涂片和培养结核杆菌,结果阳性也是可以作为确诊依据的。

- 分子生物学检测,结合其他表现诊断
分子生物学检测,是运用聚合酶链反应(PCR)技术,将标本中微量的结核杆菌DNA加以扩增,如果检测到阳性,再结合临床症状和影像学表现,也是可以确诊的。
使用的标本,可以是是痰液、分泌物和支气管灌洗液、病理组织等。

- 病理学检查,间接但可靠的依据
病理学检查,是使用病变组织来检测有没有结核的病理变化。如果发现干酪样坏死灶,通常是结核病比较常见的表现,和结核的临床表现相符,也是可以确诊的。
总之,在正常情况下,找到结核杆菌是诊断的金标准。
如果实在找不到结核细菌,则要运用医生的丰富临床经验,结合临床表现和其他检查结果,共同来确诊。

而事实上,在临床工作中,并没有多少病例符合以上的诊断标准。
这时候,就需要具体情况具体分析,作出疑似、临床和病原学等不同可靠级别的诊断了。
肺结核是由结核分枝杆菌引起的传染病,主要通过空气、飞沫经呼吸道传染。
肺结核多表现为慢性病程,症状有时候很不典型。如果在患者的痰或病理组织中没有找到结核分枝杆菌,诊断有时候比较困难。
因此,肺结核的诊断分为三种:疑似诊断、临床诊断和病原学诊断。
诊断需要从三个方面着手:流行病学依据,临床表现(包括收集到的症状,和检查到的体征),辅助检查结果(其中以痰检为最重要)。

疑似诊断
以下两种情况属于疑似诊断病例:
- 5岁以下儿童,有肺结核可疑症状,同时有与痰涂片阳性肺结核患者密切接触史;
- 胸部影像学检查显示与活动性肺结核相符的病变。

临床诊断
怀疑肺结核的患者,连续三次痰涂片阴性,但具有以下表现之一者:
- 胸部影像学显示与活动性肺结核相符的病变,患者有咳嗽、咳痰、咯血等肺结核的可疑症状。
- 胸部影像学检查显示与活动性肺结核相符的病变,PPT试验强阳性或γ-干扰素释放试验(又叫T-SPOT)阳性。
- 胸部影像学检查显示与活动性肺结核相符的病变,经过诊断性抗菌治疗两周无效,或随访检查可以排除其他原因导致的肺部疾病者。

病原学诊断
包括在痰涂片中找到结核分枝杆菌,或者痰培养出结核分枝杆菌,或者在肺穿刺的病理组织中找到结核分枝杆菌感染的依据。
在痰中或肺的病理组织中检测结核分枝杆菌核酸阳性,也可以根据情况作出病原学诊断。病原学诊断的肺结核患者属于确诊肺结核的患者。
至于前面提到的病理诊断,由于肺组织不易获得,很少应用。但是,淋巴结结核等是可以应用的。

肺结核诊断的直接依据是找到结核分枝杆菌,如果找不到细菌,要依靠流行病学、临床表现,再结合医生的临床经验来综合判断。
如果实在难以做出诊断,还可以诊断性的治疗和抗结核治疗,通过治疗的反应来判断和修正原来的诊断。

我是热爱科普的龙大夫,如果这篇文章对您有用,欢迎点赞、评论、转发、赞赏!
更多精彩科普,将不定期呈现,敬请关注!
#健康真相馆# #清风计划# #秋季养生正当时#